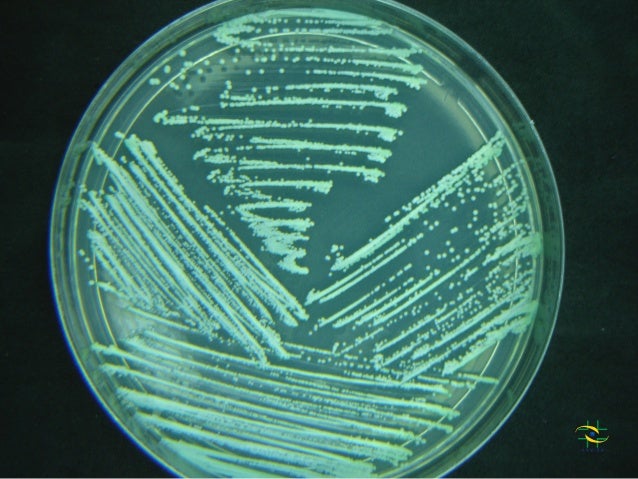
Resultado de imagem para candida cultura

INFECÇÕES VIRÓTICAS
AIDS
O que é?
A AIDS, do inglês Acquired Immune Deficiency Syndrome,
também conhecida como Síndrome da Imunodeficiência adquirida, é uma doença
causada pelo vírus HIV (Vírus da Imunodeficiência Humana), o qual age
diretamente no sistema imunológico do indivíduo e foi descrito inicialmente por
volta de 1980 sendo considerado como um agente infecto contagioso, por ser
transmitido por contato direto entre pessoas (GRECO, 2008). (Fig.1): Representação do vírus HIV.
Transmissão
Sintomas
Na grande maioria dos casos a herpes não apresenta sintomas, quando o vírus HSV-I é detectado, apresentam numerosas vesículas que causam incômodos como dor, formigamento e queimação que são agravadas quando exposto a luz do sol ou a uma baixa no sistema imunológico (GELLER et al., 2012).
Diagnóstico
Tratamento
Em caso de suspeita de herpes tanto genital quanto labial, o tratamento deve ser iniciado o mais precoce possível, com uso do Aciclovir prescrito por um médico. (FONSECA, 1999).
Bons Estudos!
![]() |
| Fig.1: Representação do Virus HIV
Transmissão
O
vírus HIV é transmitido principalmente através de relações sexuais (vaginal,
oral e anal) desprotegidas, desde que haja um meio de entrada do agente
infeccioso na corrente sanguínea do indivíduo, mas comumente conhecida na
Microbiologia e Imunologia como porta de entrada, tornando a via sexual o maior
responsável pela disseminação desse vírus. Além do contato direto com o sangue,
esperma e secreção vaginal, o HIV pode ser transmitido através do leite materno
(VERGARA et al., 2007).
Vale
ressaltar que a HIV não é transmitida pelo suor,
beijo ou picadas de mosquitos.
Sintomas
Os sintomas da AIDS variam de
organismo para organismo e pode aparecer em períodos diferentes durante a
doença. Na fase aguda os sintomas são: febre alta, diarreia crônica, faringite
(inflamação na faringe), náusea, vômito, úlceras orais, etc., e no decorrer da
doença em uma fase crônica, pode causar pneumonia e bronquites, o que pode
acabar levando a pessoa a óbito devido o sistema imunológico está debilitado
pela a ação do HIV (MINISTÉRIO DA SAÚDE, 2013). (Fig.2: Diferentes sintomas da AIDS causada pelo HIV.
![]() |
Fig. 2- Esquema referente aos diferentes sintomas da AIDS no ser
humano.
Diagnóstico
O diagnóstico
em pessoas acima de 2 anos de idades é feito a partir das análises de
anticorpos conforme a Portaria Nº 59/GM/MS, de 29 de janeiro de 2003, a
detecção desses anticorpos pode ser feita a partir da terceira semana após a
infecção, caso não seja tratado logo após a exposição ao vírus. O exame mais comum é o Elisa (exame sanguíneo
para detecção de HIV) que tem a capacidade de registrar a presença do vírus
após 20 dias depois da infecção, porém há outros exames que mostram o resultado
imediato logo após a coleta de sangue (MINISTÉRIO DA SAÚDE, 2008). (Figs. 3 e 4: Tipos de exames para
detecção de HIV).
![]() |
| Fig.3- Exame para detectar HIV no sangue |
![]() |
| Fig. Tetste para detecção de HIV np sa |
Tratamento
Apesar de não ter cura, o tratamento
do HIV consiste no uso de um coquetel (Fig.
5) de medicamentos que irão controlar a ação do vírus no sistema
imunológico, possibilitando aos HIV-positivos uma vida mais duradoura e de
qualidade, contudo, esses medicamentos podem causar alguns efeitos colaterais
como lipodistrofia (redistribuição de gordura pelo corpo), diminuição do rosto deixando-o
mais magro (Fig. 6), e em algumas
partes do corpo como nos membros, pode haver a aparição de veias e facilitar o
acúmulo de gordura na região abdominal (NEMES, 2009).
![]() |
Fig.5- Representação do coquetel usado no tratamento do HIV.![]() Fig. 6- Afinamento do rosto em consequência da ação do HIV. |
Prevenção
O modo mais eficaz para prevenir o HIV é com o uso de camisinha durante as relações sexuais (caso seja portador do vírus), assim como o uso de objetos perfuro cortantes (seringas, alicates, navalhas e outros) descartáveis.
![]() |
Fig. 7-
Campanha para o uso de preservativo.
|
HERPES
O que é?
Herpes
é uma infecção causada por o Vírus Herpes Simples (HSV) que apresenta-se em
dois tipos: (HSV) I e (HSV) II (Fig. 8),
onde o tipo I causa lesões na face, principalmente
na região labial e o tipo (HSV) II afeta a região genital. Ressaltando que o
vírus pode se manifestar de formas distintas de pessoa para pessoa (GELLER et
al., 2012).
![]() |
Fig. 8- Lesões causadas pelo HSV I (boca) e II
(pênis e vulva).
|
Transmissão
Um
dos modos mais comuns de transmissão ocorre por meio do contato íntimo como
beijo, relação sexual ou por contato com lesões que muitas vezes não são bem
esclarecidas como ocorre a transmissão (PENELLO et al., 2010).
Sintomas
Na grande maioria dos casos a herpes não apresenta sintomas, quando o vírus HSV-I é detectado, apresentam numerosas vesículas que causam incômodos como dor, formigamento e queimação que são agravadas quando exposto a luz do sol ou a uma baixa no sistema imunológico (GELLER et al., 2012).
Diagnóstico
O diagnóstico do Herpes é eminentemente clínico, através de exames como:
Citológico de Tzanck que permite a
sua visualização de células multinucleadas.
Sorologia é usada quando ocorre
desconforto sem presença de lesões.
PCR é uma técnica altamente
sensível, e pouco acessível, disponível em alguns laboratórios de referência,
para pesquisa (GELLER et al., 2012).
Tratamento
Em caso de suspeita de herpes tanto genital quanto labial, o tratamento deve ser iniciado o mais precoce possível, com uso do Aciclovir prescrito por um médico. (FONSECA, 1999).
Prevenção
·
Não compartilhar objetos pessoais
·
Lavar bem as mãos após tocar nas lesões
·
Higienizar bem a área lesionada
·
Controle do estresse
·
Sono e nutrição equilibrados (PENELLO et
al.,2010).
Todo e qualquer medicamento deve ser utilizado com prescrição médica
HEPATITE B
O que é?
A hepatite é uma grave inflamação causada por vírus que afeta o fígado
(MINISTÉRIO DA SAÚDE, 2007). Diversas hepatites como a A, B, C, D e E podem
estar presentes nos indivíduos e eles, simplesmente, não saberem por serem
infecções silenciosas (FERREIRA, 2000). A hepatite B acomete milhares de
pessoas, podendo levá-las a óbito, tendo uma grande taxa de impacto na saúde da
população (BRASIL, 2015).
Transmissão
A
transmissão pode ocorrer por via parenteral (cortes, injeções, feridas), com
objetos contaminados como escova de dente, agulhas (Fig. 11), por via sexual e de mãe para filho (vertical) (Fig. 10) podendo ocorrer durante o
parto (MINISTÉRIO DA SAÚDE, 2007).
![]() |
Fig.10 - Infecção por via vertical.
|
![]() |
Fig. 11 - Infecções por objetos perfuro-cortantes.
|
Sintomas
Quando aparecem podem apresentar
febre, urina escura, cor amarelada tanto na pele como nos olhos e náuseas (BIO-MANGUINHOS,
2014). Fig. 12: Representação dos principais sintomas.
![]() |
Fig. 12 – Principais sintomas
causados pela hepatite B.
|
Diagnóstico
O diagnóstico é conseguido através
de testes sorológicos que detecta moléculas (antígenos) como o HBsAg surgindo
após o início da infecção; logo depois podemos encontrar outra molécula,
anticorpos, do tipo IgG que permanece detectável pelo resto da vida. Caso o
HBsAg perdure por mais de seis meses a infecção é considerada crônica
(MINISTÉRIO DA SAÚDE, 2007).
Tratamento
Para infectados agudos, ou seja, no
estágio inicial não há um tratamento específico para eles e para infectados que
desenvolvem hepatite fulminante o tratamento é apenas por meio de transplante
de fígado (FERREIRA, 2000). Em indivíduos com infecção crônica o tratamento
usado atualmente é por meio do IFN (interferon) e lamivudina, o tratamento é
gratuito pelo SUS (Sistema Único de Saúde) (MINISTÉRIO DA SAÚDE, 2007).
Em mulheres gestantes o tratamento
se dá pela combinação da HBIg mais a vacina para prevenir que a hepatite B seja
repassada para o recém-nascido (BRASIL, 2015).
Prevenção
Não utilizar objetos
perfuro-cortantes (alicates, seringas, navalhas e outros) (Fig.13) que não sejam descartáveis quando for, por exemplo, na
manicure ou quando realizar tatuagens (Fig.
14) e sempre usar camisinha durante as relações sexuais; o Ministério da
Saúde ainda oferece vacinas contra a hepatite B nos postos de saúde para
recém-nascidos, crianças, adolescentes e adultos (MINISTÉRIO DA SAÚDE, 2007).

Fig. 13 – Objetos que não devem ser reutilizados.v
|
![]() |
Fig. 14 – Sempre utilizar
materiais descartáveis e nunca reutilizá-los.
|
Bons Estudos!
Texto escrito por: ¹Cinara W.F. Bezerra, ¹Maiara A. da Silva e ¹Patrícia M. da Costa.
Texto revisado por: ²Professora Dr. Marília Sales Cadena
¹ Graduandas de Bacharelado em Ciências Biológicas na Universidade Federal Rural de Pernambuco- Unidade Acadêmica de Serra Talhada (UFRPE-UAST).
² Professora adjunta da UFRPE-UAST, responsável pela disciplina de Microbiologia e Imunologia.
Referências Bibliográficas
BIO-MANGUINHOS
(Instituto de Tecnologia em Imunobiológicos). Hepatite B: sintomas, transmissão e prevenção. Disponível em
<https://www.bio.fiocruz.br/index.php/hepatite-b-sintomas-transmissao-e-prevencao>.
Acesso em 20 de fevereiro de 2017.
BRASIL. Ministério da Saúde. Protocolo Clínico e
Diretrizes Terapêuticas para Prevenção da Transmissão Vertical de HIV, Sífilis
e Hepatites Virais. Brasília: Ministério da Saúde, 2015.
FERREIRA M. S. Diagnóstico e tratamento da hepatite B.
Revista da Sociedade Brasileira de Medicina Tropical 33:389-400, 2000.
FONSECA, B.A.L. 1999 Clínica e tratamento
das infecções pelos vírus herpes simplex tipo 1 e 2. Medicina
Ribeirão Preto, 32 (1999), pp. 147-153.
GELLER, M.;
NETO, M.S.; RIBEIRO, M.G.; OLIVEIRA, L.; NALIATO, E.C.O.; ABREU, C.;
SCHECHTMAN, R.C. (2012) Herpes simples:
atualização clínica, epidemiológica
e terapêutica. J Bras Doenças Sex Transm 24:260–266
GRECO, D. B. A epidemia da Aids: impacto social,
científico, econômico e perspectivas. estudos avançados 22 (64), 2008.
MINISTÉRIO DA SAÚDE. Protocolo
clínico e diretrizes terapêuticas para manejo de infecção pelo HIV em adultos. Departamento
de DST, AIDS e Hepatites Virais. Brasília, 2013.
MINISTÉRIO
DA SAÚDE. Recomendações para terapia anti-retroviral em adultos e
adolescentes infectados pelo HIV - Programa
Nacional de DST e AIDS. 2007/2008.
MINISTÉRIO DA SAÚDE. Hepatites Virais. Brasília – DF, janeiro de 2007. Disponível em
<http://bvsms.saude.gov.br/bvs/publicacoes/07_0044_M2.pdf>. Acesso em 20
de fevereiro de 2017.
NEMES, M.I.B.;
CASTANHEIRA, R.E.L.; SANTA-HELENA, E.T.; MELHIOR, R.; CARACIOLO, J.M.; BASSO,
C.R.; et al. Adesão ao tratamento,
acesso e qualidade da assistência em AIDS no Brasil. Rev
Assoc Med Bras [Internet]. 2009 [cited 2013 set 25];55(2):207-12. Available.
PENELLO, A.M.; CAMPOS, B.C.; SIMÃO, M. et al. Herpes genital, J Brás Doenças Sex
Transm, 22 (2) (2010), pp. 64–72.
VERGARA, T. R.
C.; BARROSO, P. F. Transmissão sexual do
HIV. Tendências em HIV-AIDS, v.1, n.4, p.17-24, 2007
FONTE DAS IMAGENS
Figura 1: www.stanford.edu/.../2005gongishmail/HIV.html
Figura 2; www.google.com.br/search?q=sintomas+da+aids&espv=2&source=lnms&tbm
Figura 3: http://g1.globo.com/
Figura 4: www.google.com.br/search?espv=2&biw=1366&bih=613&tbm=isch&sa=1&q=DIA
Figura 5: www.google.com.br/search?q=coquetel+hiv&espv=2&source=lnms&tbm=isch&sa
Figura 6: https://www.google.com.br/search?espv=2&biw=1366&bih=613&tbm=isch&sa=1
Figura 7: www.google.com.br/search?q=PREVEN%C3%87%C3%83O+DA+AIDS&espv=2
Figura 8: pediatravirtual.net/herpes-genital-na-gestacao-riscos/
Figura 9: Juntospelacura.blogspot
Figura 10: Saúde UMCOMO
Figura 11: Programa Harvard
Medical School Portugal
Figura 12: Big1News
Figura 13 e 14: Tua saúde